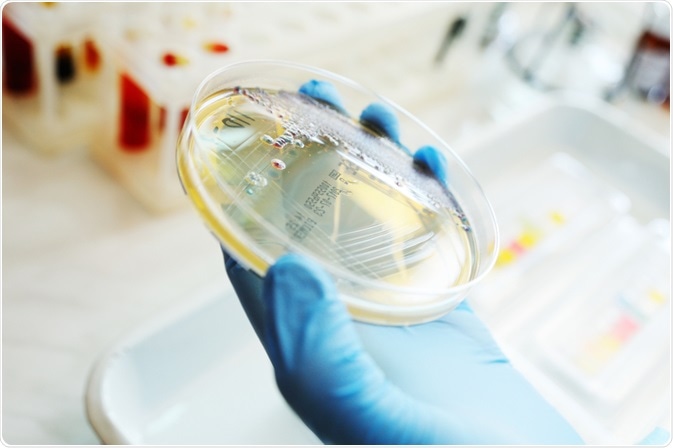
Image Credits: Evgeniy Kalinovskiy / Shutterstock.com

Cell lines are formed of cells that are able to grow indefinitely if the right conditions are met, and these can be from various sources. These cell lines are widely used in the laboratory, from studying cancer to testing potential novel treatments.
Image Credits: Evgeniy Kalinovskiy / Shutterstock.com
Image Credits: Evgeniy Kalinovskiy / Shutterstock.com
Are all cells the same?
Isogenic refers to a population with essentially identical genes. There are techniques available that can modify the DNA of cells, and this can then be used as a disease model. For example, cancer cells often have changes in their DNA, and thus this can be copied into an isogenic cell line.
Being able to modify the DNA means that it is possible to have two isogenic cell lines: one with the changes related to cancer development, and the other without those changes. This makes comparisons easier, as it can be difficult to find related cells that express genes in the same way.
How are they used?
Regulating gene expression in cell lines
Liu and co. devised a system where zinc finger protein transcription factors specific to genes of interest were used to induce gene expression in target cells. This system has high specificity, so the likelihood of other genes being affected by the zinc finger protein transcription factor is low. The expression of the zinc finger protein transcription factor can also be made inducible, so that it is possible to control when the gene of interest is activated.
The authors targeted the human parathyroid hormone receptor 1 (PTHR1), which is a G protein-coupled receptor that has a role in calcium homeostasis and bone metabolism. A zinc finger protein transcription factor that targets PTHR1 was identified, and used to induce its expression in HEK293 cells, which do not normally express PTHR1.
When the zinc finger protein transcription factor was induced, the HEK293 cells began to express PTHR1. The activity of the expressed PTHR1 was confirmed by increase in the levels of cAMP produced by the cells. The authors then used known PTHR1 ligands, and this led to the reduction in cAMP levels, thus showing that its function was reduced. The authors concluded that this approach can be used to study effects of potential therapeutic compounds on target genes.
Studying DNA mismatch repair deficiency
Errors during DNA replication can lead to changes in the DNA, including single base mismatches, base modification, and small insertion-deletion loops. To counteract the affects of these errors, DNA mismatch repair systems exists in these cells. However, these DNA mismatch repair systems can become defective, allowing these DNA changes to persist and potentially lead to cancer. In fact, it is estimated that up to 20% of solid tumors and hematologic cancers have DNA mismatch repair system deficiencies.
Bailis and co. derived an isogenic cell line system to investigate deficiency of DNA mismatch repair systems. In the study, the authors used inducible short hairpin RNA (shRNA) to prevent expression of the gene MLH1, a gene that is part of the DNA mismatch repair system. Here, when the shRNA is induced, this prevents the expression of MLH1, thus inactivating it. As the shRNA is inducible, this gave the authors the opportunity to study differences seen when MLH1 was active compared to when it was inactive.
One change the authors observed was the induction of microsatellite instability in cells when MLH1 was inactive. Microsatellite instability is another change in DNA, where repeated nucleotide sequences are either gained or lost, and the authors observed 1-3 nucleotide shifts at the BAT-26 mononucleotide repeat. However, this did not change the global gene expression pattern in the cell lines.
Predictive cancer biomarker discovery
In cancer biology, predictive biomarkers give information about the effect of treatment. Haagensen and co. utilized isogenic cell lines to seek out potential predictive biomarkers in response to four therapeutic drugs.
The authors found that the response varied according to how the cells were cultured. For example, in 2D culture they found that KRAS+/- and PIK3CA+/- cells were more sensitive to MEK inhibitors compared to their isogenic parental cells or other mutants. However, in a 3D system KRASG13D/- and PIK3CAE545K/- xenografts were sensitive to one of the MEK inhibitors, but “tumors” derived from parental cells were not sensitive at all.
This shows that, by the use of isogenic cell lines, response to MEK inhibitors are not only influenced by mutations in KRAS and PIK3CA, but also by how these cells are grown.
Sources
sciencedirect.com. Cell Lines https://www.sciencedirect.com/topics/neuroscience/.
Gillet, J.-P. et al. (2013) The Clinical Relevance of Cancer Cell Lines. Journal of the National Cancer Institute https://www.ncbi.nlm.nih.gov/pmc/articles/PMC3691946/
merriam-webster.com. Isogenic https://www.merriam-webster.com/dictionary/isogenic
amsbio.com. Isogenic Cell Lines http://www.amsbio.com/isogenic-cell-lines.aspx
Liu, P.-Q. et al. (2005) Isogenic Human Cell Lines for Drug Discovery: Regulation of Target Gene Expression by Engineered Zinc-Finger Protein Transcription Factors. Journal of Biomolecular Screening https://journals.sagepub.com/doi/abs/10.1177/1087057104272663
Bailis, J. M. et al. (2013) An Inducible, Isogenic Cancer Cell Line System for Targeting the State of Mismatch Repair Deficiency. PLOS One journals.plos.org/plosone/article?id=10.1371/journal.pone.0078726
Oldenhuis, C. N. et al. (2008) Prognostic versus predictive value of biomarkers in oncology. European Journal of Cancer https://www.ncbi.nlm.nih.gov/pubmed/18396036
Haagensen, E. J. et al. (2016) Pre-clinical use of isogenic cell lines and tumours in vitro and in vivo for predictive biomarker discovery; impact of KRAS and PI3KCA mutation status on MEK inhibitor activity is model dependent. European Journal of Cancer https://www.sciencedirect.com/science/article/pii/S0959804915011569
Further Reading
Last Updated: Jul 1, 2023